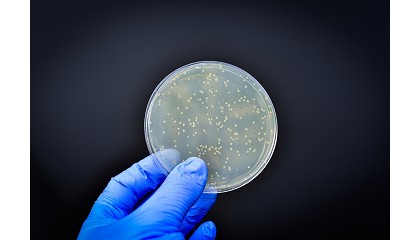

Resultados de la búsqueda "transferencias"
Rafael Ruiz Nieto, nuevo CEO de MP Ascensores - 04/02/2026

transferencia de conocimiento y la representación corporativa, lo que permitirá una transición gradual alineada con la visión estratégica del grupo. MP Ascensores, con más de 1.200 empleados y presencia en más de 100 países
Más del 70% de los genes de resistencia a los antibióticos están en la cadena alimentaria - 07/08/2025
Transferencia de resistencia entre bacterias Un hallazgo especialmente relevante es que cerca del 40% de estos genes están asociados a elementos genéticos móviles que pueden facilitar su transferencia entre bacterias
Interacciones dinámicas y seguras - 17/11/2023

transferencia de este tipo en entornos de producción inteligentes. Su enfoque se basa en el ajuste de campos de protección dinámicos alrededor del AGV durante la transferencia de materiales. Los sistemas
Ideko cierra un año récord en pedidos y facturación con 12,9 millones de euros - 21/05/2025

transferencia tecnológica y consolidación sectorial Ideko cierra un año récord en pedidos y facturación con 12,9 millones de euros En un contexto económico global marcado por la incertidumbre, el centro
El Gobierno refuerza las capacidades de España en ciberseguridad y ciberdefensa con 1.157 millones de euros - 07/05/2025

transferencias de crédito a tres ministerios. El primer acuerdo autoriza una transferencia de crédito por importe de 189 millones de euros desde el Ministerio para la Transformación Digital y de la Función
SmartWOP: el software inteligente, sencillo y rápido de Homag - 15/05/2025

Transferencia directa de los datos de SmartWOP a las aplicaciones y los asistentes digitales de Homag Mediante un solo clic, podrá generar todos los datos de producción, como programas CNC, listas
Las ventajas del acero inoxidable para los intercambiadores de calor de tubo corrugado - 24/04/2025

transferencia de calor puede no ser el más higiénico o el más fácil de limpiar. Aunque en términos simples el cobre y las aleaciones de cobre/níquel suelen tener la mayor
Soluciones avanzadas en filtración de agua para mejorar la eficiencia de plantas termosolares de aceite térmico - 02/09/2024

transferencia de calor, como el aceite térmico, estas plantas capturan y transfieren la energía solar para la generación de electricidad. Dentro de esta tecnología, los sistemas de filtración de agua
Cómo manejar el bienestar ambiental en explotaciones de ovino y caprino lechero: resultados finales del proyecto TechCare - 10/11/2025

transferencia de los resultados del proyecto a la cadena de valor de ovinos y caprinos en distintos países europeos. Dr. Gerardo Caja, profesor emérito del Departamento de Ciencia Animal y los Alimentos
Mayor eficiencia y precisión utilizando la placa aislante térmica adecuada - 01/12/2025

transferencia por contacto. Para una protección eficaz y fiable, se necesita un balance térmico en el ciclo de moldeo por inyección. La energía se introduce mediante refrigeración y, posiblemente, tecnología
Una empresa surgida del CSIC desarrollará chips flexibles basados en carbono para monitorizar sensores - 11/03/2025

transferencia de conocimiento, agrega Isabel Gavilanes, gestora de Transferencia en la Vicepresidencia de Innovación y Transferencia del CSIC. Desde nuestra Vicepresidencia impulsamos tecnologías innovadoras en sectores clave en España, como
La elección de intercambiadores de calor para residuos viscosos y lodos - 11/09/2025

transferencia de calor pueden convertirse en un problema en los evaporadores tradicionales. Con Unicus, la acción de raspado mantiene la superficie de intercambio limpia y conserva una alta eficiencia de transferencia
Digitalización y conocimiento científico impulsan la evolución del sector jamonero - 18/02/2026

transferencia de conocimiento redefinen el modelo competitivo del jamón Digitalización y conocimiento científico impulsan la evolución del sector jamonero La jornada La innovación al servicio de la industria jamonera, celebrada
Las variedades gallegas Carapucho, Carmeliña y Maruxiña pueden comenzar a plantarse y comercializarse - 13/03/2025

Transferencia, y amparándose en las investigaciones llevadas a cabo por el grupo Viticultura, Olivo y Rosa (VIOR) de la Misión Biológica de Galicia (MBG). Redacción Interempresas El proceso acaba de finalizar
El equipo 4Space UniOvi, nominado al Young Talent Award 2026 de la EduNet World Association - 11/02/2026

transferencia internacional de conocimientos. Con la fundación EduNet, Phoenix Contact ha creado una iniciativa que cubre por igual los requisitos de las universidades y la industria en cuanto a actualidad
Jornadas Interempresas y AEFA organizan en Valladolid el III Congreso de Gestión Sostenible del Suelo - 18/09/2024

transferencia de conocimiento y networking que explorará las mejores prácticas para la conservación del suelo y cómo aprovechar todo su potencial agronómico. Redacción Tierras / Interempresas La tercera edición del Congreso
Interempresas Media y ETSAV impulsan la asignatura ToSCA: un puente entre la universidad y la realidad profesional - 16/02/2026

transferencia de conocimiento: desde la presentación de sistemas constructivos por parte de patrocinadores hasta la defensa de propuestas ante un jurado multidisciplinar, los estudiantes han podido experimentar de primera mano
Ligna.Stage 2025 refuerza su apuesta por la innovación y la sostenibilidad en el 50º aniversario de la feria - 29/04/2025

transferencia de conocimiento, ejes del programa en Hannover Ligna.Stage 2025 refuerza su apuesta por la innovación y la sostenibilidad en el 50º aniversario de la feria En el 50 aniversario
Transferencia de conocimiento con realidad aumentada industrial - 11/03/2024

Transferencia de conocimiento con realidad aumentada industrial - 11/03/2024: Publirreportaje Transferencia de conocimiento con realidad aumentada industrial La Realidad Aumentada (RA) facilita la transferencia de conocimiento y blinda tu empresa ante
Micro y nanotecnologías abren una nueva vía para la detección rápida de patógenos en la industria cárnica - 18/02/2026

transferencia de estos desarrollos hacia sistemas robustos, compatibles con condiciones reales de procesado y con los requisitos de validación industrial y normativa. Control microbiológico en línea y digitalización de la seguridad
